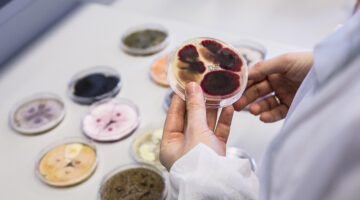

NIB continues cooperation with Novozymes
NIB and the Danish biotech company Novozymes A/S have signed a DKK 750 million (approx. EUR 101 million) loan to finance the company’s research and development (R&D) expenditures 2021.
The 10-year-maturity loan supports the company’s R&D activities in consumer biosolutions, as well as agriculture and industrial biosolutions.
Novozymes is a high intensity R&D enterprise, with approximately 13% of revenue reinvested in research annually. The company holds more than 6,500 active and pending patents and launches 15-20 new products every year. The latest investments will strengthen the company’s market leading portfolio across several business areas.
This is NIB’s sixth loan agreement with Novozymes.
“With continuous investments in innovation, Novozymes has established itself as one of the global leaders in biotechnology. Our long-lasting partnership supports the company’s further growth, which can be beneficial not only for the region, but also the entire biotech industry,” says André Küüsvek, NIB President and CEO.
Novozymes is a global biotechnology company with a strong focus on enzyme production. The company’s biosolutions cover a wide range of applications from the removal of trans-fats in food to advancements in renewable energy sources. Novozymes employs over 6,100 people globally, more than 20% of whom work with R&D activities.
NIB is an international financial institution owned by eight member countries: Denmark, Estonia, Finland, Iceland, Latvia, Lithuania, Norway and Sweden. The Bank finances private and public projects in and outside the member countries. NIB has the highest possible credit rating, AAA/Aaa, with the leading rating agencies Standard & Poor’s and Moody’s.
For further information, please contact:
Mr Seppo Halttunen, Senior Client Executive, Services & Consumer,
at +358 10 618 0411, Seppo.Halttunen@nib.int
Mr Vytautas Brazaitis, Communications Officer, at +358 10 618 0235, Vytautas.Brazaitis@nib.int
